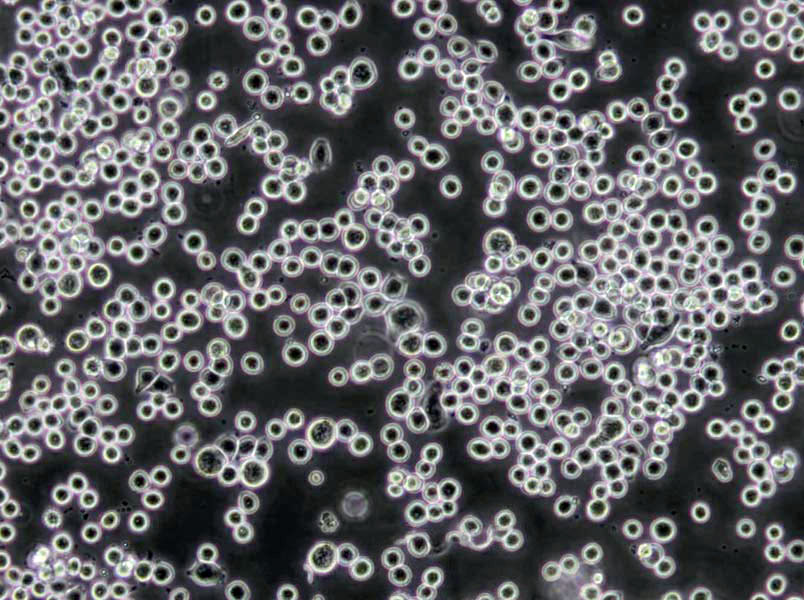
THLE-2 Cells|肝永生化需消化细胞系

"THLE-2 Cells|肝永生化需消化细胞系
Cell形态:上皮Cell样
Cell生长:贴壁
体内Cell培养及其操作步骤:【瘤Cell悬液接种】1)无菌选取生长良HAO(有光泽,淡红色)瘤组织或对数生长期培养瘤Cell;2)在PBS中将瘤组织剪碎后用匀浆器研磨,经80~100目筛网过滤成Cell悬液;3)培养Cell应用PBS洗两遍;4)计数并调整Cell浓度至107~108/ml;5)常规消毒后,于接种部位(通常为背部或腋窝腹股沟皮下)用医用注射器皮下潜行一段后注入Cell悬液(0.1ml/部位,>106Cell)。初次接种成功率低,Cell数尽可能多一些;6)次日注意观察动物一般情况。初次接种一般有一段较长的潜伏期,以后随着传代潜伏期逐渐缩短,Zui后固定为一个相对稳定的时间。【腹水瘤的建立与腹水瘤的接种】将实体瘤Cell直接种于小鼠腹腔、腹壁或其他部位,引起腹水,腹水中含有瘤Cell,将这种腹水反复传代,即可成为腹水瘤。初次传代时,腹水常呈血性(含大量红Cell),反复传代后腹水逐渐变成乳白色。腹水瘤的接种过程如下。1)将冻存或培养的腹水瘤Cell离心和洗涤,进行Cell计数;2)消毒动物,左下腹穿刺接种106腹水瘤Cell;3)接种腹水瘤Cell后约7~12d,待小鼠腹部明显膨大。用碘酒棉球消毒小鼠腹部,用9号针头抽取腹水,也可行腹部解剖后,用滴管吸取。每只小鼠可抽3~5ml;4)抽取的腹水经3000rpm离心15min,收集上清,分装冻存备用。
THLE-2 Cells|肝永生化需消化细胞系
Cell物种来源:或鼠源等其它物种来源
H-929Cells;Cell背景资料:详见相关文献介绍;Cell传代方法:保持Cell密度在5×105—1×106 cells/ml之间,每周换液2—3次;Cell生长特性:悬浮生长 ;Cell形态特性:淋巴母Cell样;相关Cell有:C3H/10T1/2 CL8Cells、ZR751Cells、NCI-H661Cell
H-929Cells;Cell背景资料:详见相关文献介绍;Cell传代方法:保持Cell密度在5×105—1×106 cells/ml之间,每周换液2—3次;Cell生长特性:悬浮生长 ;Cell形态特性:淋巴母Cell样;相关Cell有:C3H/10T1/2 CL8Cells、ZR751Cells、NCI-H661Cell
AQ-MelCells;Cell背景资料:详见相关文献介绍;Cell传代方法:1:2-1:4传代,2-3天换液1次。;Cell生长特性:贴壁生长;Cell形态特性:星形的;相关Cell有:SUM149PTCells、NCI522Cells、Jurkat E6.1Cell
[Cell产品包装]鲜活Cell:T25培养瓶(一瓶)或冻存Cell:1ml冻存管(两支)
Cell背景资料:详见相关文献介绍
Cell传代方法:1:3-1:6传代;2-3天换液1次。
预防Cell污染的注意事项:实验进行前,超净台用紫外灯照射30-60min,然后用75%酒精擦拭超净台台面,并开启超净台风扇运转10min左右再开始实验操作。实验用品用75%酒精擦拭后才能放入超净台内;实验用品用完应移出超净台,以利于气流的流通。实验完成后用75%酒精擦拭超净台台面。每次操作只处理一种Cell;即使不同Cell使用相同的培养基也不要共享同一瓶培养基,避免Cell间的交叉污染。操作时小心取用无菌的物品,避免污染。勿碰触吸管尖头,不小心碰触后应立即更换;不要在打开的容器瓶口正上方操作,容器打开后,倾斜45°操作,操作完成后及时盖上瓶盖。CO2培养箱的清洁是较易被忽视的地方,应1-2个月对培养箱定期进行清洁消毒。先用75%酒精擦拭培养箱内壁、隔板、水盘2-3次,用双蒸水清洗,再用酒精棉球擦拭一遍,后紫外灯照射4h以上。水盘内加入无菌水(应每周更换),待培养箱内温度、湿度、CO2浓度稳定后再放入Cell。定期清洗或更换超净台过滤膜、预滤网。
THLE-2 Cells|肝永生化需消化细胞系
Cell来源说明:来源于RCB、ATCC、KCLB、DSMZ、ECACC、INCell、ScienCell、ECACC、JCRB、Asterand、ICLC等知名Cell库
COR-L279Cells;Cell背景资料:详见相关文献介绍;Cell传代方法:1:2-1:3传代;每周换液2-3次。;Cell生长特性:贴壁或悬浮,详见Cell说明书部分;Cell形态特性:详见Cell说明书;相关Cell有:NS1Cells、Caov-4Cells、HCC0015Cell
QGP-1Cells;Cell背景资料:胰腺癌;男性;Cell传代方法:1:2-1:3传代;每周换液2-3次。;Cell生长特性:贴壁;Cell形态特性:详见Cell说明书;相关Cell有:BALB 3T3 clone A31Cells、HSC-1Cells、JB6 Cl 30Cell
CAL12TCells;Cell背景资料:详见相关文献介绍;Cell传代方法:1:2-1:3传代;每周换液2-3次。;Cell生长特性:贴壁或悬浮,详见Cell说明书部分;Cell形态特性:详见Cell说明书;相关Cell有:L6Cells、SEG1Cells、NCI H747Cell
Cell生长特性:贴壁生长
造成实验室Cell污染常见情况总结:Cell培养中Zui常见污染的是细菌、真菌和支原体污染。Cell一旦污染,大多数较难处理。那么,哪些情况我们不注意的话就会造成Cell污染呢?我们根据常见Cell培养实验分析总结下。【违规操作】1)为节省时间,有已经用超净台四个多小时,不开紫外灭菌30min,酒精擦拭后直接开始试验;2)器材或者溶液很久没用,未检测是否污染而直接使用;离心管多次使用,枪头为了方便交叉使用;3)超净台不点酒精灯;点了酒精灯放在右上角,而你在左下角做试验;4)不带手套,徒手操作;5)Cell培养间配备枪式移液器、手术器械、离心机、冰箱等专用仪器设备以及专用的实验服和拖鞋,未定期消毒。专用物品被带出传代Cell使用。培养Cell过程中使用的所有实验用具,如移液管、一次性枪头、一次性塑料离心管、冻存管等未按要求灭菌使用(通常需121°CGAO压灭菌20分钟后37%烤干备用)。超净台和桌面,东西太多太乱:超净台不是储物箱,什么培养皿、各种规格的板子、枪头就不要堆在超净台!这样就会有许多紫外线顾不到的卫生死角。传代Cell其他的桌面,切忌东西堆积如山,不要将酒精棉球、标签纸、牛皮纸买来后全部堆在传代Cell!一不小心“飘”进你的Cell培养板里,Cell就会养的不HAO,啥时候死了都不知道!【培养箱太久没清洁】Cell污染了,并非直接扔了培养皿就不管了,首先你还得看看这个恒温培养箱里其他培养皿或孔板里的Cell是否污染,如果有而且HAO几个板子都有类似的污染块,那很可能是培养箱中的水或者空气污染了,得给培养箱做个大扫除,重新酒精消毒,照紫外;孵箱里的水,水没了要记得加,还得记得十天半个月的就用酒精擦擦托盘。【传代Cell多口杂,难管理】在传代Cell这种卫生要求GAO,多了,不确定因素多了,难以保证试验在无菌条件下操作。出入试验室,实验服当风衣穿,不扣纽扣,不戴,就容易造成Cell污染;超净台做实验时,喜欢说话聊着做试验,要是还不带口罩,里面就有很多细菌等着去攻击你的Cell呢!
MASMCCell类似产品::MDA-MB-468-REDCell、K562/ADRCell、RPMI8226Cell
HEC-251Cell类似产品::GM17346Cell、SV40-MES13Cell、MDA-MB361Cell
PIG1Cell类似产品::L78Cell、FTC133Cell、SKMEL24Cell
C8D1ACell类似产品::NCIH1930Cell、HELA-GFPCell、Dunn LM8Cell
HPDE6c7Cell类似产品::B16F1Cell、BCPAPCell、RCC 786-OCell
MGH-U1Cell类似产品::OCI-AML2Cell、IM-9Cell、GM02219CCell
SKCO 1Cell类似产品::TE32Cell、JJN3Cell、MDA-MB 231Cell
TE353.SKCell类似产品::Calu-3Cell、P3/NSI/1-AG4-1Cell、BC-021Cell
CL-34Cell类似产品::MDA134Cell、IOSE-29Cell、Hep 3BCell
NCIH1435Cell类似产品::CHG-5Cell、293-GPCell、JIIICell
SASCell类似产品::GA-10-Clone-4Cell、NPACell、H-650Cell
NCIH2291Cell类似产品::Mouse Colon 38Cell、WB F344Cell、KE37Cell
PaCa2Cell类似产品::NTera-2D1Cell、118MGCell、OCILY19Cell
Plaepi 34Cell类似产品::MDA PCa 2bCell、NBL_SCell、CA922Cell
Plaepi 34Cell类似产品::MDA PCa 2bCell、NBL_SCell、CA922Cell
RGCsCell类似产品::SK-MES-1Cell、C81-61Cell、3T6 Swiss AlbinoCell
THLE-2 Cells|肝永生化需消化细胞系
Ramos 2G6 4C10Cell类似产品::PANC-04-03Cell、TE-85Cell、Statens Seruminstitut Rabbit CorneaCell
PTK2Cell类似产品::JIIICell、OVCAR3Cell、MDA-MB-435 SCell
RF/6ACell类似产品::HT-29/CX-1Cell、RGM1Cell、LU65Cell
MHCC-LM3Cell类似产品::C-28I2Cell、JROECL19Cell、Hs934TCell
RT-BM 1Cell类似产品::B95.8Cell、SK MEL-28Cell、CemT4Cell
HCOCell类似产品::SNU368Cell、Wien 133Cell、SJSA-1Cell
JURKAT E-6.1Cell类似产品::MELCell、NCIH647Cell、Balb/c3T3Cell
RPMI-7951Cell类似产品::HDQP1Cell、SBC-3Cell、TC-1 [Mouse lung]Cell
J774Cell类似产品::LuCL4Cell、SKM1Cell、H-2066Cell
Mv.1.LuCell类似产品::YACCell、BC-027Cell、LICCFCell
RPVSMCCell类似产品::SUM-149Cell、NCI-H1651Cell、NCIH1975Cell
HTh 74Cell类似产品::MDA-MB-415Cell、GM00637Cell、IOSE-MarCell
NCI-H2171Cell类似产品::AN3Cell、Walker/LLC-WRC 256Cell、RCK8Cell
HEK293T/17Cell类似产品::SKNSHCell、University of Arizona Cell Culture-893Cell、SUM149PTCell
FDCP-1Cell类似产品::M21Cell、HCC1599Cell、GT1-1Cell
INS-1Cell类似产品::BALL1Cell、22Rv1Cell、COLO 206Cell
Hs 729Cell类似产品::SK Hep1Cell、YES-2Cell、JB-6 Cl 30Cell
HCC1937Cell类似产品::JROECL 21Cell、SHSY-5YCell、DMS53Cell
BIU87Cell类似产品::H2591Cell、NCI-H358Cell、HSAEC1-KTCell
Metastatic Variant-522Cells;Cell背景资料:肺腺癌;女性;Cell传代方法:1:2-1:3传代;每周换液2-3次。;Cell生长特性:贴壁;Cell形态特性:详见Cell说明书;相关Cell有:NCI-H2291Cells、GH 3Cells、Granta 519Cell
A-1847Cells;Cell背景资料:卵巢癌;女性;Cell传代方法:1:2-1:3传代;每周换液2-3次。;Cell生长特性:贴壁;Cell形态特性:详见Cell说明书;相关Cell有:SL-29Cells、HuTu-80Cells、6-T CEMCell
GLC-15Cells;Cell背景资料:详见相关文献介绍;Cell传代方法:1:2-1:3传代;每周换液2-3次。;Cell生长特性:贴壁或悬浮,详见Cell说明书部分;Cell形态特性:详见Cell说明书;相关Cell有:LLCMK2Cells、INS-1ECells、He-LaCell
FF-WT-BJCells;Cell背景资料:详见相关文献介绍;Cell传代方法:1:2传代;Cell生长特性:贴壁生长;Cell形态特性:成纤维Cell样;相关Cell有:hTERT-HPNECells、R 2 CCells、H-4Cell
WEHI3BCells;Cell背景资料:白血病;BALB/c;Cell传代方法:1:2-1:3传代;每周换液2-3次。;Cell生长特性:悬浮;Cell形态特性:详见Cell说明书;相关Cell有:OS-732Cells、HepG2/C3ACells、MadisonCell
OCI-Ly 8Cells;Cell背景资料:弥漫大B淋巴瘤;Cell传代方法:1:2-1:3传代;每周换液2-3次。;Cell生长特性:悬浮;Cell形态特性:详见Cell说明书;相关Cell有:K562/ADPCells、MOLT3Cells、MDA-MB-436Cell
hTERT-HPNECells;Cell背景资料:胰腺导管;HGNC-TERT转化;男性;Cell传代方法:1:2-1:3传代;每周换液2-3次。;Cell生长特性:贴壁;Cell形态特性:详见Cell说明书;相关Cell有:OVCAR-8/ADRCells、LUDLU1Cells、Lewis lung carcinomaCell
HIT clone T15Cells;Cell背景资料:胰岛βCells;SV40转化;Cell传代方法:1:2-1:3传代;每周换液2-3次。;Cell生长特性:贴壁;Cell形态特性:详见Cell说明书;相关Cell有:NL20Cells、SVEC4-10Cells、NW-38Cell
H6c7Cells;Cell背景资料:详见相关文献介绍;Cell传代方法:1:2-1:3传代;每周换液2-3次。;Cell生长特性:贴壁或悬浮,详见Cell说明书部分;Cell形态特性:详见Cell说明书;相关Cell有:Y-1Cells、253JB-VCells、LL/2Cell
Rat-2Cells;Cell背景资料:成纤维Cells;自发永生;Fischer 344;Cell传代方法:1:2-1:3传代;每周换液2-3次。;Cell生长特性:贴壁;Cell形态特性:详见Cell说明书;相关Cell有:KMS18Cells、Kit225-K6Cells、526Cell
SL1Cells;Cell背景资料:详见相关文献介绍;Cell传代方法:1:2-1:3传代;每周换液2-3次。;Cell生长特性:贴壁或悬浮,详见Cell说明书部分;Cell形态特性:详见Cell说明书;相关Cell有:Cates-1BCells、NCI-H2347Cells、TFK1Cell
SK-MEL-2-LUCCells;Cell背景资料:详见相关文献介绍;Cell传代方法:1:2-1:3传代;每周换液2-3次。;Cell生长特性:贴壁或悬浮,详见Cell说明书部分;Cell形态特性:详见Cell说明书;相关Cell有:VECells、CORL105Cells、B16-F10Cell
PCI:SG231Cells;Cell背景资料:肝内胆管癌;男性;Cell传代方法:1:2-1:3传代;每周换液2-3次。;Cell生长特性:贴壁;Cell形态特性:详见Cell说明书;相关Cell有:NCTC-1469Cells、NCI747Cells、A10Cell
EACCells;Cell背景资料:艾氏腹水瘤;Cell传代方法:1:2-1:3传代;每周换液2-3次。;Cell生长特性:半贴壁;Cell形态特性:详见Cell说明书;相关Cell有:U-373 MGCells、Acanthosis Nigricans 3rd attempt-CArcinomaCells、Swiss-3T3Cell
HRIFCells;Cell背景资料:详见相关文献介绍;Cell传代方法:1:2-1:3传代;每周换液2-3次。;Cell生长特性:贴壁或悬浮,详见Cell说明书部分;Cell形态特性:详见Cell说明书;相关Cell有:CV-1Cells、Madin-Darby Bovine KidneyCells、MCF-10ACell
COLO-320HSRCells;Cell背景资料:该Cell1984年建系,源自一位33岁患有大肠腺癌男性经5-fu治疗后的腹水。;Cell传代方法:1:2传代。3天内可长满。;Cell生长特性:半贴壁生长;Cell形态特性:详见Cell说明书;相关Cell有:UACC-812Cells、G-401Cells、NIH3T3Cell
A2008Cells;Cell背景资料:宫颈鳞癌;女性;Cell传代方法:1:2-1:3传代;每周换液2-3次。;Cell生长特性:贴壁;Cell形态特性:详见Cell说明书;相关Cell有:OsACLCells、AU-MelCells、H-35 ReuberCell
U2OSCells;Cell背景资料:骨肉瘤;女性;Cell传代方法:1:2-1:3传代;每周换液2-3次。;Cell生长特性:贴壁;Cell形态特性:详见Cell说明书;相关Cell有:Hela-Ap-1Cells、BIU-87Cells、KLN-205Cell
huH 1Cell类似产品::Lewis lung carcinomaCell、D283 MedCell、343MGCell
MV-522Cell类似产品::SUM 102Cell、451-LUCell、Caki2Cell
J-82Cell类似产品::293EBNACell、MDA-175Cell、NCI-H2172Cell
SUM149Cell类似产品::KBM7Cell、PA317Cell、SP-2/0-AG14Cell
MV4-11Cell类似产品::EBTr (NBL-4)Cell、AC16 [Human hybrid]Cell、SKLU01Cell
MDA157Cell类似产品::Mink LungCell、T-cell Acute Lymphoblastic Leukemia-1Cell、UCLA NPA-87-1Cell
Panc203Cell类似产品::SCHCell、HCASMCCell、Human podocyteCell
BIU87Cell类似产品::H2591Cell、NCI-H358Cell、HSAEC1-KTCell
A498Cell类似产品::H-196Cell、C2-C12Cell、OSC19Cell
LoVoCell类似产品::KYSE 270Cell、SNU878Cell、NCI-H1105Cell
Wistar Institute-38Cell类似产品::PK(15)Cell、WM115Cell、PC 61-5-3Cell
MKN-45Cell类似产品::SHSY-5YCell、HPB/ALLCell、MCF-7Cell
TGW-nuCell类似产品::SKNEPCell、OCI Ly10Cell、TE-85Cell
SNUC1Cell类似产品::HSC3Cell、PY8119Cell、AML-EOL-1Cell
L540Cell类似产品::MES-SA/Dx5Cell、P31 FUJCell、RS(4;11)Cell
KuramochiCell类似产品::OCI-AML-4Cell、OP9Cell、SNU-C1Cell
N-2aCell类似产品::SUDHL16Cell、B16-BL6Cell、NCI.H226Cell
PC9Cell类似产品::CNE1Cell、HME-1Cell、SU-DHL-6Cell
NCI-H1105Cell类似产品::NCI-H1694Cell、RKO-E6Cell、Sup T-1Cell
OV 2008Cell类似产品::FOXNYCell、HFF-1Cell、NCI-H78Cell
HeLa/S3Cell类似产品::Lilly Laboratories Cell-Porcine Kidney 1Cell、NCTC1469Cell、GP-293Cell
MDA-kb2Cell类似产品::COLO-699Cell、ketr 3Cell、P3/NS1/1-Ag4-1Cell
L-132Cell类似产品::CAL851Cell、EVSA/TCell、OCI/AML5Cell
U266Cell类似产品::MV-4-11Cell、H1993Cell、AZ-521Cell
LNCaP C4-2Cell类似产品::SW480ECell、DI TNC-1Cell、NK92Cell
H-1930Cell类似产品::PaCa2Cell、HS-294-TCell、253J-BVCell
AU 565Cell类似产品::Det 562Cell、OCM1Cell、WC00097Cell
HL-60 Clone 15Cell类似产品::HHUACell、Roswell Park Memorial Institute 7666Cell、TE-6Cell
NCIH820Cell类似产品::HBECell、SNU-668Cell、SKBr3Cell
THLE-2 Cells|肝永生化需消化细胞系
SEG1Cell类似产品::NCI H929Cell、MDA-435Cell、Jurkat E6Cell
GM17219Cell类似产品::SUM159Cell、BT483Cell、Hs-852-TCell
A498Cell类似产品::H-196Cell、C2-C12Cell、OSC19Cell
U031Cell类似产品::HEL299Cell、NCIH1385Cell、CCF-STTG1Cell
ACC-2Cell类似产品::NCIH226Cell、Tb 1 Lu (NBL-12)Cell、OE19Cell
Centre Antoine Lacassagne-27Cell类似产品::MDA435Cell、Tokyo Medical and Dental university 8Cell、Mv1LuCell
MASMCCell类似产品::MDA-MB-468-REDCell、NIH/3T3Cell、NCI-H1963Cell
SNU182Cell类似产品::HEM-LCell、HCC941122Cell、SKG-IIIaCell
"